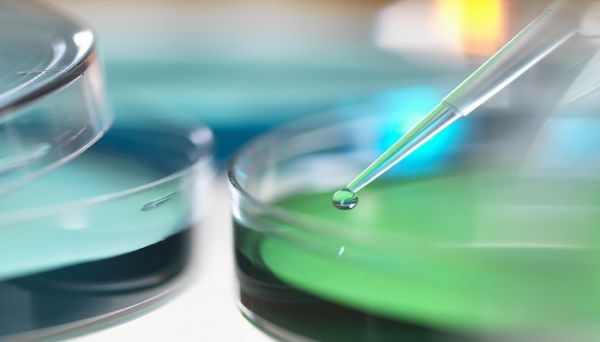

成长教育

2025-02-0939阅读

2025-02-0934阅读

2025-02-0938阅读

2025-02-0937阅读

忽如一夜春风来千树万树梨花开形容什么 忽如一夜春风来千树万树梨花开写的是
2025-02-0947阅读

2025-02-0950阅读

2025-02-0942阅读

2025-02-0950阅读
氯化铝与过量氢氧化钠反应方程式 氯化铝与过量氢氧化钠反应方程式是什么
2025-02-0950阅读

2025-02-0949阅读